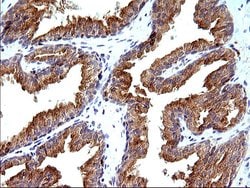
SCAMP2 Monoclonal Antibody (OTI2F1), TrueMAB , OriGene 100 &mu;L; Unconjugated:Antibodies,
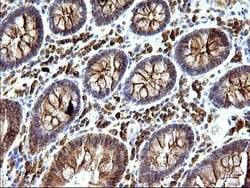
SCAMP2 Monoclonal Antibody (OTI2F1), TrueMAB , OriGene 100 &mu;L; Unconjugated:Antibodies,

missing translation for 'onlineSavingsMsg'
Learn More
Learn More
SCAMP2 Monoclonal Antibody (OTI2F1), TrueMAB™, OriGene
Mouse Monoclonal Antibody
Brand: Origene Technologies TA506992

This item is not returnable.
View return policy
Description
Secretory carrier membrane proteins (SCAMPs) are proteins that are components of post-Golgi membranes. These proteins are implicated to function in membrane trafficking. In fibroblasts, SCAMPs are concentrated in compartments that are involved in the recycling of cell surface receptors and endocytosis. In neurons, SCAMPs are associated with synaptic vesicles, secretion granules and transporter vesicles. SCAMPs are composed of four central transmembrane regions and a cytoplasmic tail. Of the five known SCAMPs, SCAMPs 1-3 contain cytoplasmic N-terminal regions with NPF repeats. NPF repeats are found to interact with EH domain proteins that function in budding of transport vesicles from the plasma membrane or the Golgi complex. SCAMPs 4 and 5 lack the N-terminal NPF repeats. SCAMPs 1-4 are all ubiquitously coexpressed while SCAMP 5 is only detectable in the brain. Studies show that SCAMP 5 is expressed late in development which is coincident with expansion of mature synapses.Specifications
| SCAMP2 | |
| Monoclonal | |
| 1 mg/mL | |
| PBS with 1% BSA, 50% glycerol and 0.02% sodium azide | |
| O15127 | |
| SCAMP2 | |
| Full length human recombit protein of human SCAMP2 produced in HEK293T cell. | |
| 100 μL | |
| Primary | |
| Human | |
| Antibody | |
| IgG1 |
| Immunocytochemistry, Immunofluorescence, Immunohistochemistry (Paraffin), Western Blot | |
| OTI2F1 | |
| Unconjugated | |
| SCAMP2 | |
| secretory carrier membrane protein 2 | |
| Mouse | |
| Affinity Chromatography | |
| RUO | |
| 10066 | |
| -20° C, Avoid Freeze/Thaw Cycles | |
| Liquid |
Product Content Correction
The Fisher Scientific Encompass Program offers items which are not part of our distribution portfolio. These products typically do not have pictures or detailed descriptions. However, we are committed to improving your shopping experience. Please use the form below to provide feedback related to the content on this product.
Product Title
Spot an opportunity for improvement?Share a Content Correction